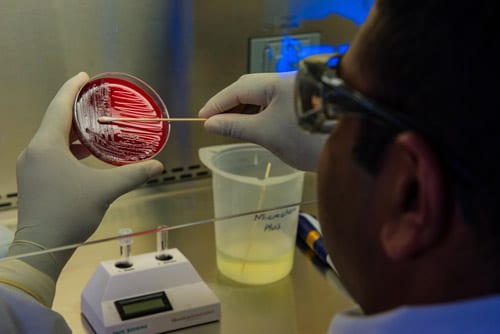
man is making tests in a laboratory

Sciences and Applied Sciences
Study Sciences and Applied
Sciences at our various destination
Find out where you can study Master’s level courses in Sciences and Applied Sciences.

Sport Sciences and Physical Education